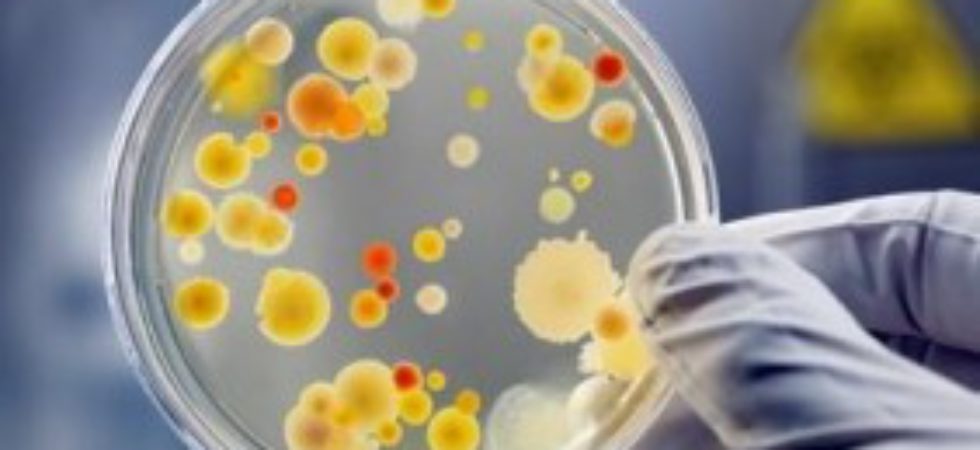

Пам’ятка для населення “Профілактика ботулізму”
 За оперативною інформацією Державної служби України з питань безпечності харчових продуктів та захисту споживачів наприкінці травня поточного року в м. Києві було зареєстровано один летальний випадок захворювання на ботулізм та два випадки захворювання на ботулізм у мешканців м. Києва, які вживали в їжу в’ялену рибу промислового виробництва, придбану в торгівельній мережі міста.
За оперативною інформацією Державної служби України з питань безпечності харчових продуктів та захисту споживачів наприкінці травня поточного року в м. Києві було зареєстровано один летальний випадок захворювання на ботулізм та два випадки захворювання на ботулізм у мешканців м. Києва, які вживали в їжу в’ялену рибу промислового виробництва, придбану в торгівельній мережі міста.
Що таке ботулізм і як вберегтися від цієї хвороби?
Ботулізм – це дуже небезпечне і в багатьох випадках смертельне токсичне інфекційне захворювання, яке виникає при вживанні продуктів, заражених мікробом групи клостридій. Клостридії у великій кількості присутні в грунті, де можуть існувати довгі роки, а також у кишечнику багатьох тварин, звідки з фекаліями потрапляють у грунт. Харчові продукти, забруднені цим мікробом і недостатньо оброблені, стають причиною захворювання на ботулізм.
Токсин клостридій – ботулотоксин – починає вироблятися тільки без доступу кисню. Зазвичай це відбувається в консервованих, щільно закупорених продуктах, в черевці засоленої риби, в овочах, рибі та м’ясі, засолених великими шматками, у великій тарі, до дна якої не проникає кисень. Багато випадків отруєння ботулотоксином виникають від вживання консервованих грибів.
У питаннях профілактики ботулізму основним є дотримання чистоти сировини. Тому чим чистіше відмито городину перед консервуванням, чим ретельніше промита риба перед засолом, тим менше ймовірність потрапляння до продукту збудника ботулізму. Гриби складно повністю звільнити від мікрочастинок ґрунту, тому не рекомендується консервувати їх у герметично закритих банках у домашніх умовах. При домашньому консервуванні, особливо овочів, що містять мало природної кислоти, необхідно додавати за рецептурою оцтову, лимонну кислоти, тому що збудник ботулізму не любить кисле середовище. Важливо добре стерилізувати банки й кришки безпосередньо перед закладкою в них продуктів. Якщо можливо, то потрібно прогрівати домашні консерви перед вживанням, бо при 80 градусах ботулотоксин руйнується.
Найменше здуття кришки — причина для категоричної відмови від вживання в їжу вмісту даної банки.
Також необхідно категорично виключити придбання виготовлених у домашніх умовах консервів, в’яленої, копченої, солоної риби й інших продуктів харчування в місцях несанкціонованої торгівлі у приватних осіб.
У випадку появи симптомів захворювання слід негайно звернутися до лікаря за медичною допомогою, так як зволікання може призвести до смерті.
Пам’ятайте: хворобу легше попередити, ніж лікувати. Будь-яке отруєння не проходить безслідно. Бережіть своє здоров’я і здоров’я близьких, а особливо дітей. Прислухайтесь до вищевказаних порад.